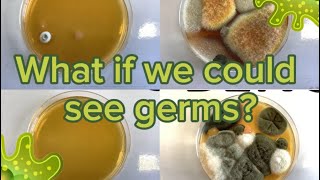

What if we could see germs? 🦠 Reellife Science 🧬 video
Online izle ve mp4 mp3 formatlarinda yukle

Videonun muddeti: 1:21
What if we could see germs? 🦠 Reellife Science 🧬 videosu mp4 ve mp3 yuklemek ucun hazirdir
Diqqet! Siz Mp4 yukle ve ya Mp3 yukle duymesine basdiqdan sonra eger sistem sizi reklam sehifesine atarsa o zaman derhal geri qayidib emeliyyati tekrar edin ve faylin yuklemek ucun hazir olmasini gozleyin
Videodan Mp4 Yukle
Videodan Mp3 Yukle-1
Videodan Mp3 Yukle-2
Oxshar Axtarishlar
 What if you could see germs?
What if you could see germs? How To See Germs Spread Experiment (Coronavirus)
How To See Germs Spread Experiment (Coronavirus) What If You Never Washed Your Hands
What If You Never Washed Your Hands What if we could see germs? 🦠 Reellife Science 🧬
What if we could see germs? 🦠 Reellife Science 🧬 Vinegar VS Bacteria under the microscope!
Vinegar VS Bacteria under the microscope! Germs for Kids | Learn all about bacteria, viruses, fungi, and protozoa
Germs for Kids | Learn all about bacteria, viruses, fungi, and protozoa See Germs! Hand Washing Science Experiment
See Germs! Hand Washing Science Experiment WHAT THINGS ACTUALLY LOOK LIKE UNDER A MICROSCOPE
WHAT THINGS ACTUALLY LOOK LIKE UNDER A MICROSCOPE White Blood Cell Fights GIANT GERM!
White Blood Cell Fights GIANT GERM!
Video Mp4 Mp3Azwap.Biz
Azwap.Biz 2021-2023


 What if you could see germs?
What if you could see germs? How To See Germs Spread Experiment (Coronavirus)
How To See Germs Spread Experiment (Coronavirus) What If You Never Washed Your Hands
What If You Never Washed Your Hands What if we could see germs? 🦠 Reellife Science 🧬
What if we could see germs? 🦠 Reellife Science 🧬 Vinegar VS Bacteria under the microscope!
Vinegar VS Bacteria under the microscope! Germs for Kids | Learn all about bacteria, viruses, fungi, and protozoa
Germs for Kids | Learn all about bacteria, viruses, fungi, and protozoa See Germs! Hand Washing Science Experiment
See Germs! Hand Washing Science Experiment WHAT THINGS ACTUALLY LOOK LIKE UNDER A MICROSCOPE
WHAT THINGS ACTUALLY LOOK LIKE UNDER A MICROSCOPE White Blood Cell Fights GIANT GERM!
White Blood Cell Fights GIANT GERM!